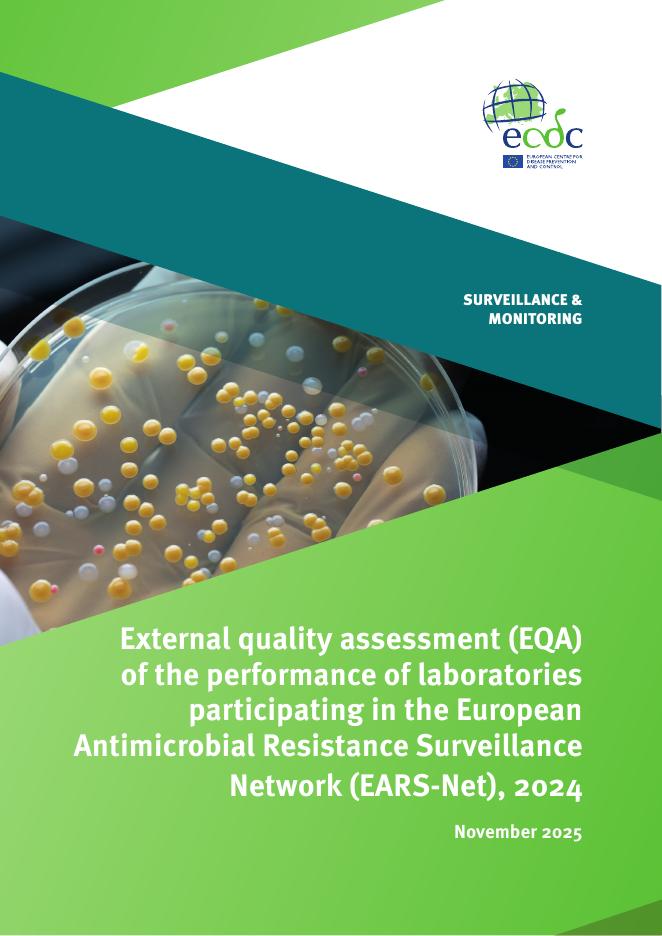

✅当您赞助下载文档后,您只能预览,并不意味着购买了版权,不得用于商业用途(直接或间接盈利),下载后请24H内删除。
✅本站所有内容均由热心网友分享赠送,本站不对文档的完整性、权威性及正确性做任何保证或承诺!文档内容仅供预览参考。
✅十六年老网站,赞助会员全站免币!
✅本站已经工信部、公安部备案,真实可信!
1、打开文档需要使用基本的办公软件,如Word、Office、WPS、Pdf、Cad、Rar、Zip等。
2、如遇下载失败、解压失败、文档缺失等问题,请通过【反馈】按钮提交。



















